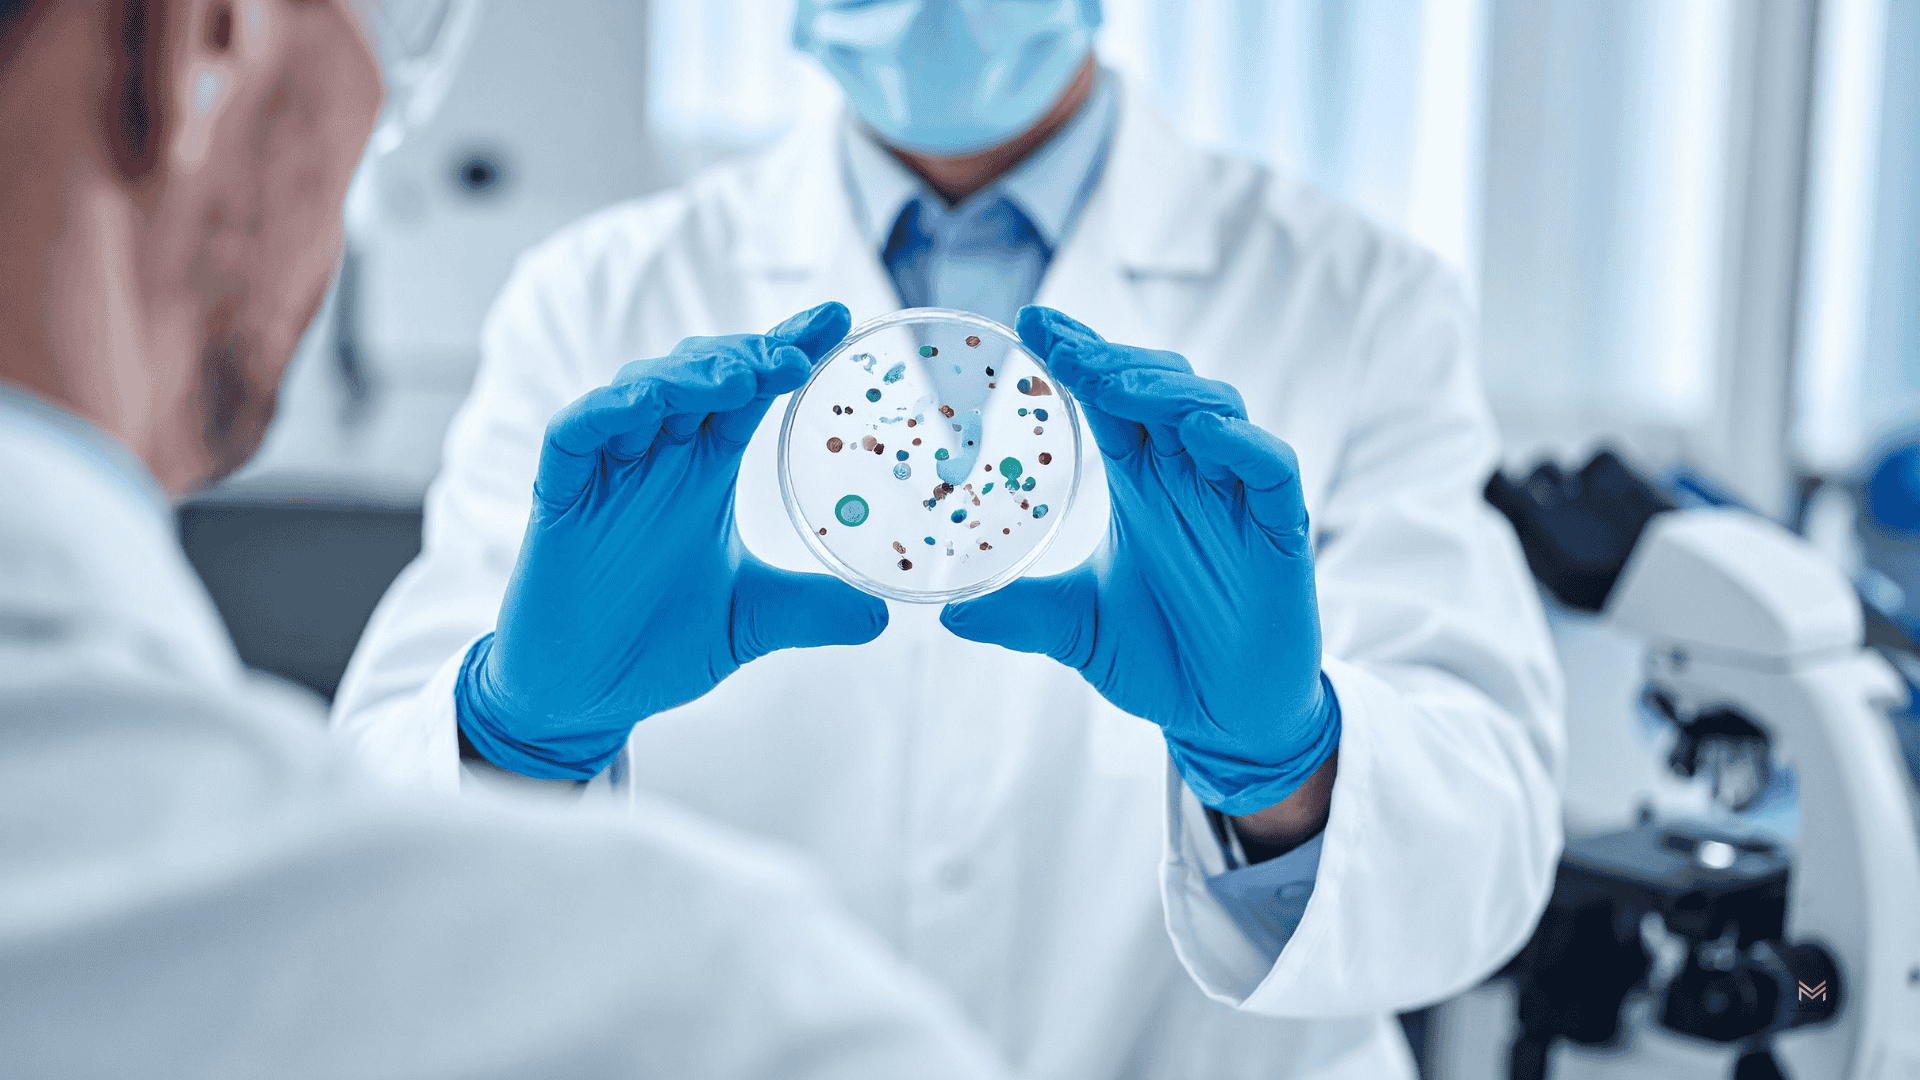

Advanced, patient-centered treatment for joint, spine, and nerve conditions — with less surgery, less medication, and better results.
At Medici Orthopaedics & Spine, you’re more than your MRI or X-ray.
Whether you're dealing with an old sports injury, recovering from surgery, or managing chronic pain, we take time to hear your story and create a personalized recovery plan that helps you heal — fully and actively.

Same-day and next-day visits often available.
Our fellowship-trained physicians identify the true source of your pain.
We stay with you from diagnosis through recovery — including rehab, therapy, and return to activity.
Just choose your location, and we’ll guide you from there.
Book an appointmentWe care for active adults, athletes, weekend warriors, and anyone living with pain. From sports injuries and arthritis to spine conditions and nerve damage, we treat a full spectrum of orthopaedic and pain-related issues:

Our team uses advanced, evidence-based techniques that support healing while minimizing downtime.
We combine multiple therapies to maximize your outcome — because healing works best when it's integrated. Explore Our Treatments
Collaborative care from top specialists in orthopaedics, interventional pain, physical therapy, sports rehab, and neuropsychiatry.








.png)


.png)


.png)










.png)


.png)


.png)


Read the latest insights from our providers to help you stay active, informed, and in control of your health.

Pain can persist even when an MRI appears normal because many underlying causes—like muscle imbalances, nerve sensitivity, and joint dysfunction—don’t show up on imaging. Effective diagnosis requires looking beyond structural findings to understand how the body moves, functions, and responds to stress. A comprehensive, personalized approach is often necessary to identify hidden pain triggers and achieve lasting relief.
Read full article
Old injuries can resurface when underlying damage was never fully healed, often triggered by aging, scar tissue, or repetitive strain. Many traditional treatments only manage symptoms, leaving the root cause unaddressed and leading to recurring pain. Regenerative medicine focuses on stimulating the body’s natural healing process to repair damaged tissue, reduce inflammation, and support long-term recovery.
Read full articleOur team delivers specialist care at convenient locations across Metro Atlanta:
Get expert tips on injury recovery, pain relief, joint health, and movement strategies—straight from our Fellowship-Trained team.